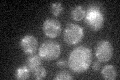
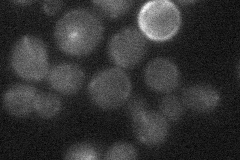
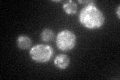
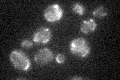

View description
Subunit of the trimeric GatFAB AmidoTransferase(AdT) complex; involved in the formation of Q-tRNAQ; required for remodeling of ER caused by Hmg2p overexpression; similar to bacterial GatA glutamyl-tRNA amidotransferase
Localization:
Intensity:
Fold change:
Significance:
-
C’ GFP library in SD
mitochondria19.52 -
N' NOP1pr-GFP in SD

cytosol51.3891 -
N' TEF2pr-mCherry in SD

punctate25.0782 -
N' NATIVEpr-GFP in SD
below threshold20.3253 -
N' TEF2pr-VC and Cyto-VN in SD

#N/A0 -
C’ GFP library in SD+DTT
mitochondria23.891.22No -
C’ GFP library in SD+H2O2

mitochondria18.40.94No -
C’ GFP library in Starvation Media
mitochondria21.531.1No -
C’ GFP library on the background of Pup2-DaMP

mitochondria -
C’ GFP library on the background of CCT mutant

mitochondria19.29440.987884No
